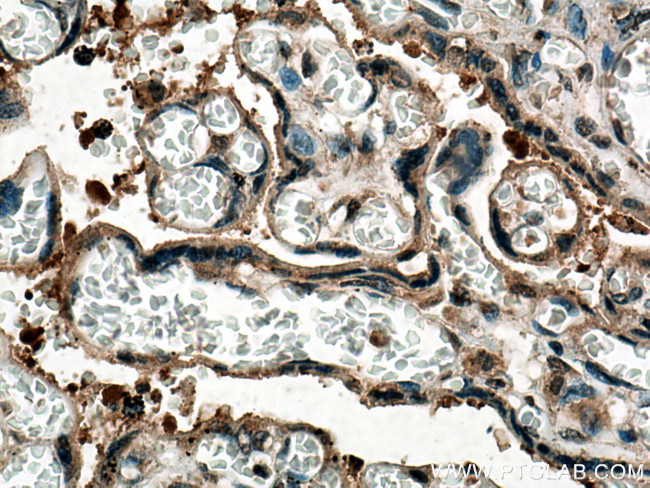
PTPN14 Antibody in Immunohistochemistry (Paraffin) (IHC (P))

Search
Proteintech
PTPN14 Monoclonal Antibody (1B8C8)
{{$productOrderCtrl.translations['antibody.pdp.commerceCard.promotion.promotions']}}
{{$productOrderCtrl.translations['antibody.pdp.commerceCard.promotion.viewpromo']}}
{{$productOrderCtrl.translations['antibody.pdp.commerceCard.promotion.promocode']}}: {{promo.promoCode}} {{promo.promoTitle}} {{promo.promoDescription}}. {{$productOrderCtrl.translations['antibody.pdp.commerceCard.promotion.learnmore']}}
产品信息
67744-1-IG
种属反应
宿主/亚型
分类
类型
克隆号
抗原
偶联物
形式
浓度
纯化类型
保存液
内含物
保存条件
运输条件
产品详细信息
Aliquoting is unnecessary for -20°C storage.
靶标信息
The protein encoded by this gene is a member of the protein tyrosine phosphatase (PTP) family. PTPs are known to be signaling molecules that regulate a variety of cellular processes including cell growth, differentiation, mitotic cycle, and oncogenic transformation. This PTP contains an N-terminal noncatalytic domain similar to that of band 4.1 superfamily cytoskeleton-associated proteins, which suggested the membrane or cytoskeleton localization of this protein. The specific function of this PTP has not yet been determined.
仅用于科研。不用于诊断过程。未经明确授权不得转售。
生物信息学
蛋白别名: cytoskeletal-associated protein tyrosine phosphatase; Protein-tyrosine phosphatase pez; Tyrosine-protein phosphatase non-receptor type 14
基因别名: PEZ; PTP36; PTPD2; PTPN14
UniProt ID: (Human) Q15678
Entrez Gene ID: (Human) 5784